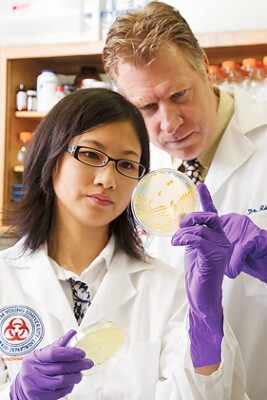
woan-lowe.jpg

Life In Abundance
"I have tremendously benefited from my experience here"
June 13, 2011
Original article can be found here.
Mentored BYU students thrive
When Woan Lowe joined The Church of Jesus Christ of Latter-day Saints as a teenager in St. Louis, Missouri, her family stopped talking to her and withheld financial support for her anticipated college education. So Lowe dropped her extracurricular high school activities and got a job to save for her future.
As a sophomore at Brigham Young University, Lowe participated in a mentored lab. “I had no experience, but I dove in and was fascinated by the process of research,” she says.Mentoring happens all across campus; one-on-one or in small groups in labs and studios, faculty mentors are improving the BYU experience for thousands of students each semester.Lowe is now a senior and will graduate this fall with a degree in molecular biology. She says, "some people have dreams of attaining stardom or of climbing the corporate ladder. Instead of these, I want to be I want to be a scientist." She will begin a BYU master's program this fall.Since Lowe has been a student at BYU, her mother has softened toward her beliefs and even attended Lowe’s wedding reception. Says Lowe: “I’ve never regretted my decision to join the Church. Looking back I’m grateful for the experiences that I’ve had as a Latter-day Saint and as a BYU student.”To those who have aided her education she says: “I am truly grateful. Because of you an education at BYU was attainable, and because of your generosity I had a better BYU experience.”
Determined to succeed
Students come to BYU for many reasons, but recent graduate Jarom Chung based his decision to attend the Y largely on thrift. As a high school student, Chung worked in a bank as a loan officer assistant. The job led him to choose BYU because of its high value-to-cost ratio. “I saw that graduating free of debt was a good goal.”

Once he arrived at BYU, Chung determined to get the most value he could. Initially his efforts were focused on preparing for medical school. To strengthen his chances of acceptance, he joined a lab. “I caught the research bug and realized that my mind is geared to problem solving,” he says.
Much of his research time has been spent in assistant professor Marc Hansen’s lab, seeking to understand how cancer cells spread. With this experience, he applied for and was accepted to many of the nation’s top biomedical sciences graduate schools. He begins his PhD program at Harvard this fall.“I have tremendously benefited from my experience here. I am grateful for the scholarships I received,” says Chung. “I’ve worked to get by, and BYU has taught me that working hard with a positive attitude will take me far.”
A hopeful future

Fascinated by research into the causes and treatment of Alzheimer’s disease, sophomore Matthew Bailey, paid to attend a life science symposium where fellow BYU students were presenting. He listened and watched, and at the end of the day Professor Keoni Kauwe asked Bailey whose lab he worked in. “I was hoping to work in yours,” Bailey replied.
In Kauwe’s lab, Bailey has been part of a consortium of researchers from institutions including Harvard University, the Mayo Clinic, and Johns Hopkins School of Medicine. “Currently there is no cure for Alzheimer’s disease, but as researchers we are approaching an understanding of its causes from a genetic level,” says Bailey. This summer in Paris he will present his findings at an international conference on Alzheimer’s disease.
A mentor has made all the difference for Bailey. “Because of my work and association with Dr. Kauwe, I’m on a life path that will be fulfilling and challenging,” he says. “My BYU education and experience have prepared me for graduate school. I am grateful for the generosity and support that made this possible.”
The marrow of life
When Connecticut native Arielle Sloan considered where to attend college, she decided to go west. “Where people hiked real mountains and knew what Mormons were,” she says.

Sloan’s academic passion has always been epidemiology, the study of health at the population level. As a sophomore, she began working in a lab. Later professor Ray Merrill invited Sloan to participate in his research. Her studies on the effects of homelessness on infants and mothers will be published in a scholarly journal.
Sloan is preparing to serve an LDS mission in Milan, Italy, after which she will return to Provo to complete her bachelor’s degree. She plans to pursue a master’s degree in public health and a doctorate in epidemiology. “I’m eager to research disease patterns and to teach,” she says. “I want to share what I learn with those who can use it to live longer, more fulfilling lives.
"BYU has a real focus on ensuring the spiritual, physical, and emotional health of its students. Professors, students, mentors, and fellow students have helped me succeed. Beyond those I interact with, I know that many people are actively investing in my future. Thank you."